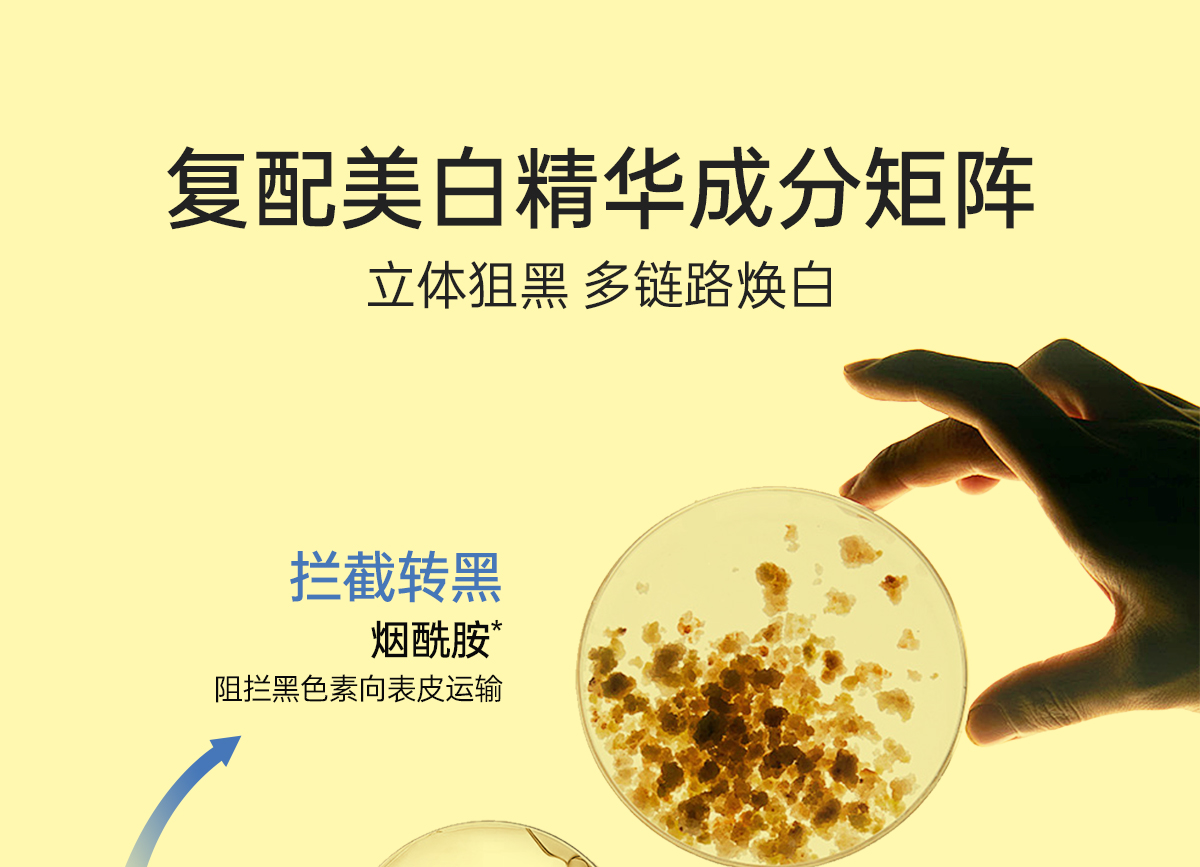

【支持1支10g小样试用】【遇光更耐晒 美白更稳白】柳丝木活力御光美白防晒乳
¥149.00
限时折扣
原价:¥199.00
| 运费: | ¥ 0.00-999.00 |
| 库存: | 67 件 |
商品详情
⚠️支持1支10g小样🉑试用!🉑试用7天内不合适全部产品「含试用的小样」退回、其他正装不要拆封、原包装退回全额退款!

- 小醒官方旗舰店 (微信公众号认证)
- 扫描二维码,访问我们的微信店铺
- 随时随地的购物、客服咨询、查询订单和物流...














